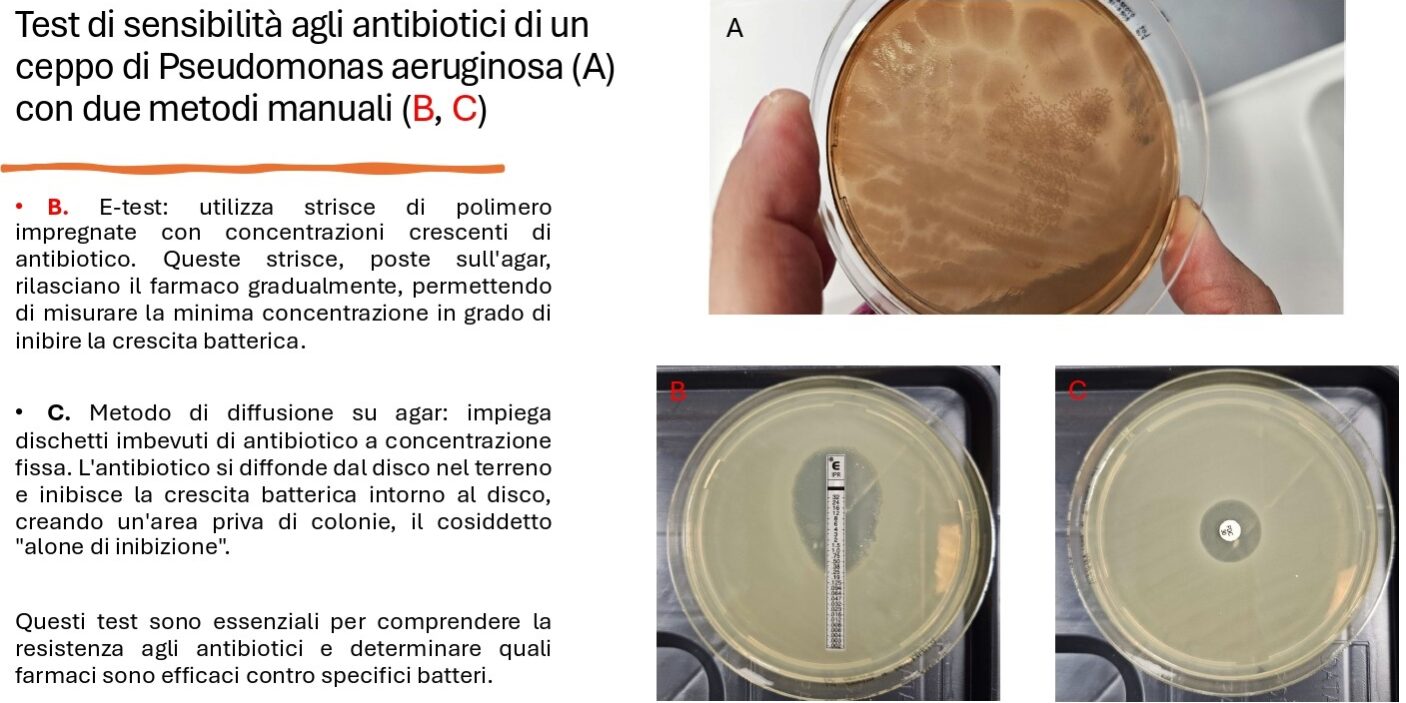

Antibiotici vs Batteri: La Sfida Continua!
314 314 people viewed this event.
Gli antibiotici possono davvero curare ogni infezione? E cosa accade quando se ne abusa?
In questa dimostrazione interattiva, esploreremo come i batteri stiano diventando sempre più resistenti agli antibiotici e cosa la scienza sta facendo per combatterli. Scopriremo i segreti della resistenza batterica e quanto sia fondamentale l’uso corretto degli antibiotici per preservare la loro efficacia. Un viaggio affascinante tra scienza e innovazione per comprendere la battaglia cruciale per la salute futura.
A cura di Susanna Oddera e Emanuela Marcenaro (DIMES – Università di Genova)